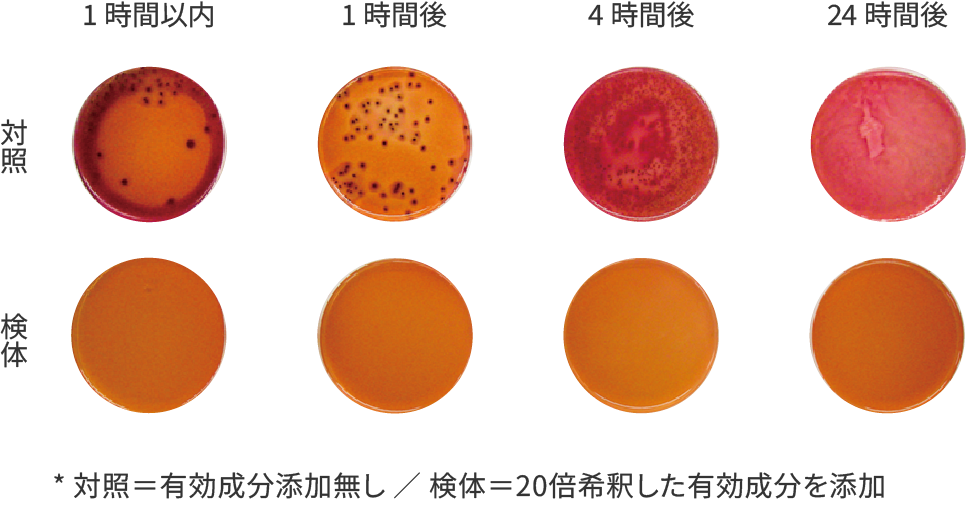

生分解スプレー
除菌
抗菌
消臭

Our Solution生分解による問題解決を
微生物と酵素が有機化合物を分解して自然に還す「生分解」。分子レベルで解体されることで、菌も・ウイルスも・悪臭もなくなり、無害化されます。当社では【微生物+酵素】による生分解、【高い効果】と【身体・環境への優しさ】とを両立した問題解決をご提案します。
手指・調理場・衣類・壁面・空間など、あらゆるものにお使いいただけます。化学薬品は含んでいませんので、肌や素材を傷めることもありません。
スプレーが乾いた後も有効成分が表面に留まり、分解効果を発揮し続けます。ノロウイルスなどの食中毒予防にも有効性が確認されています。
衣類・寝具等の臭いから、トイレなどの水回り、ペットショップや豚舎まで … ニオイ成分も化合物。分解することで消臭が可能です。

Bio-degradation Spray生分解スプレー Josh
分解を促進する酵素と、酵素を生成する微生物とを高濃度で配合。
「除菌・消臭」は「ジョシュ」におまかせ!
除菌・抗菌
分解・消毒、抑制効果24時間持続
菌やウイルスを分解・不活化し、増殖抑制効果は24時間持続します。特筆すべき点として、食中毒で問題となるノロウイルスにも有効である点が挙げられます。かつ、100%天然成分で安全※です。手指の除菌・消毒から、まな板などの調理器具、加湿器での噴霧などにも安全にご利用いただけます。
(※LD50値:14,700mg/kg。ビタミンCより高い生体安全性)
不活化試験 *1
除菌・消臭
悪臭の元の元を分解・長時間抑制
大腸菌はタンパク質・アミノ酸を分解し、結果として様々な不快臭物質を生成します。有効成分を添加した検体は、試験開始後速やかに大腸菌が分解され、24時間経過後も発生・増殖が認められません。一方、有効成分を添加しなかった比較対照群の24時間後を見ると、菌の増殖が飽和状態に至っており、菌数をカウントできないほどにまでなっていることがわかります。
大腸菌による試験 *1
除臭・脱臭
空間・臭気ガスに対する消臭効果
- アンモニア(尿・汗などの臭いの元)
- トリメチルアミン(魚臭・生ゴミ臭の元)
- 硫化水素(腐卵臭・生ゴミ臭の元)
についての実験データです。Josh封入環境下では、ニオイの原因物質が分解され、数値に顕著な差が見られます。(グラフをクリックで拡大表示)(グラフを拡大してご覧ください)
- 第三者機関による試験データ
- *1: 財団法人 日本食品分析センター
- *2: 地方独立行政法人 大阪府立産業技術総合研究所
アルコールや次亜塩素酸ナトリウムとの違い
100%天然成分 = 高い安全性・手荒れなし
広く用いられる「化学薬品」
除菌・消毒に広く利用されているアルコール(エタノール)。その強力な脱脂作用でエンベロープウイルスの脂質膜を破壊・不活化することから、コロナ禍以降利用される機会が激増しました。
近年また食中毒のニュースが増えているノロウイルスは、脂質膜を持たないノンエンベロープウイルスであり、アルコールでは不活化できません。希釈した次亜塩素酸ナトリウムを用いての消毒が一般的です。
アルコール、次亜塩素酸ナトリウムともに刺激の強い化学薬品であり、生体への毒性を持ちます。アルコールは皮脂を奪いバリア機能を破壊し、肌荒れの原因となります。次亜塩素酸ナトリウムは吸入しないように注意する必要があり、アルコールよりも更に気を遣うことは周知のとおりです。
天然成分:微生物+酵素で生分解
当社の生分解スプレー:Josh(ジョシュ)の成分は、天然土壌由来の微生物と酵素。人体・生体・物体に対しての刺激性がなく大変安全であるという点で、アルコールや次亜塩素酸ナトリウムなどとは対照的です。
生分解という特性上、スプレー後は分解対象に瞬間的・破壊的に作用するのではなく、化学薬品よりもややゆるやかに作用します。
たとえば手指消毒のためにアルコールをスプレーすると、30秒から1分程度で多くの菌やエンベロープウイルスが失活しますが、成分の揮発とともにその効果も失われます。一方、生分解スプレーは、数分から数十分かけて分解を進め、乾いた後も効果が長時間持続する(有効成分が表面に留まり、除菌・防臭・ウイルス失活を行い続ける)といった違いがあります。
Application用途・事例


※ 拭き取ってしまうと、成分が「拭いた側」のタオルなどの方に移ってしまいますのでご注意ください。(→ タオル側に効果が現れることになります)


ただし生分解の特性上、分解・不活化には数分~数時間を要します(対象となる菌・ウイルスによって必要な時間が異なります)。
即効性のある化学薬品(アルコール、次亜塩素酸系)と、うまく使い分けていただくのが良いと思います。


また、壁紙などに染み付いたニオイにも効果を発揮します。かつ、天然成分ですので素材にも優しく、色落ち等の心配がありません。


頻繫に使うスーツなども、夜スプレーしておけば朝にはニオイの原因物質(皮脂、加齢臭の原因となるノネナール等)が分解されています。菌の増殖も抑えますので、翌日も防臭効果が持続します。


カビの繁殖を抑える効果もありますので、数日おきにスプレーを繰り返すことでより効果を実感いただけると思います。


天然成分なので、ペットの健康を害しないところもポイントです。第三者機関のテストで、ビタミンCよりもはるかに生体安全性が高いというデータが出ています。


芳香剤でニオイを上書きして誤魔化すのとは真逆のアプローチで、ニオイの原因物質を分解してしまいましょう。
愛車がより快適な空間になりますよ!


夜スプレーしておくことで、朝までにニオイを分解&翌日も菌の繁殖を長時間抑制します。
使い続けるほどに効果ありますので、是非実感してみてください。


僅かの手間とコストで … お手持ちのマスクが「単なるフィルター」から、「分解・増殖抑制作用をもつ機能性フィルター」にグレードアップします。


加齢臭の原因となるノネナールの増殖抑制効果もあり、夏でもスーツを脱げないビジネスマンにも好評です。


ランニングコスト的にお値打ちなことも、プロの現場で喜ばれるポイントです。


天然成分100%で化学物質を含まないないことも、病棟や介護施設といったシーンに向いているポイントですね。
などなど …
FAQよくある質問
- 消臭について:すぐ効きますか? 効果は長持ちしますか?
- スプレー後、有効成分の酵素がニオイ原因物質を速やかに分解し始めます。対象の分子によって分解速度が異なります(脱臭試験グラフを参照ください)。また、スプレーの水分が揮発した後も有効成分が対象物表面に留まり、効果が持続します(24時間もしくはそれ以上)。
- 噴霧してからどれくらいでウイルスが不活化しますか?
- インフルエンザウイルスについては30分以内、ノロウイルス(同系・代替のネコカリシウイルス)では6時間以内(但し、実験データの減少速度から推定される値としてはおおよそ60分以内)の不活化を確認しています。生分解という特性上、瞬間的に作用するのではなく、ウイルスを分解しきるまでに多少時間を要します。対象物に「あらかじめ噴霧しておく」形で使用いただければ幸いです。
- 一度にどれくらいの量をスプレーするのが適正でしょうか? また、用途によって量を調整する必要がありますか?
- 対象物の表面がしっとり濡れる程度にスプレーしてください。なお、アルコールのような速乾性はありませんので、かけすぎると水分が垂れます(過剰にスプレーする必要はありません)。水分が自然乾燥で乾いた後、有効成分が対象物表面に留まって菌・ウイルス・におい成分の分解を行います。
- 業務用に使用したいため、まとまった量を購入したいです。ボリュームディスカウントの対応は可能ですか?
- ありがとうございます。「お問い合わせ」ページ内のメールフォームに必要事項を記入のうえご送信いただければ幸いです。内容を確認後、担当者よりご連絡させていただきます。